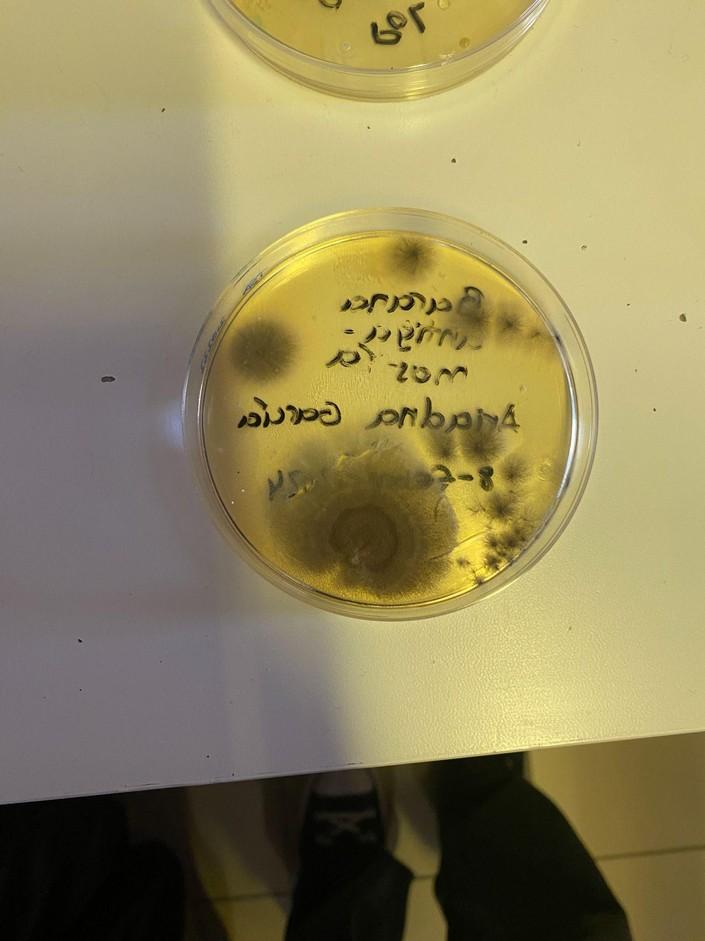
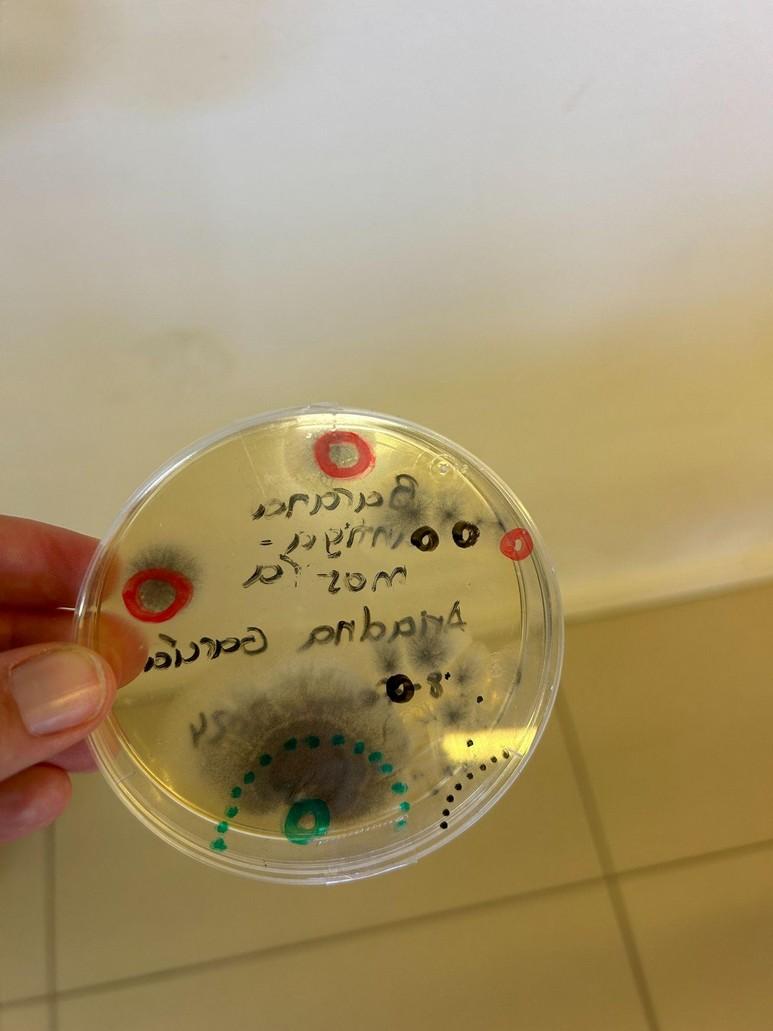
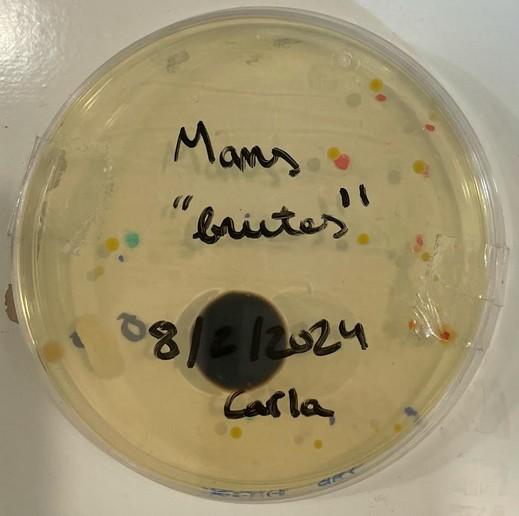
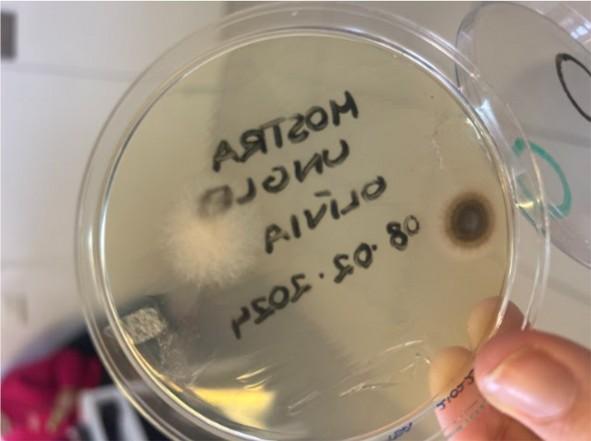

“Només l’invisible, explica el visible”
Com fer art amb un microscopi?
Una mostra il·lustrada de la natura en els límits del que és visible

Projecte Sant Jordi 2024
Promoció Emily Davison

“Només l’invisible, explica el visible”
Com fer art amb un microscopi?
Una mostra il·lustrada de la natura en els límits del que és visible

Projecte Sant Jordi 2024
Promoció Emily Davison
Enguany els nois i noies de la Promoció Emily Davison hem volgut conèixer el regne dels microorganismes, tan invisibles a l’ull nu com essencials per a la vida.
Hem pres mostres de la nostra quotidianitat i les hem observat al microscopi. Se’ns ha revelat una realitat oculta que ens ha captivat des del primer moment. Des de la biologia, les matemàtiques, la història, l’art ens hem fet preguntes, hem creat expectatives de treball, hem experimentat amb textures, hem discernit sobre els patrons i la geometria de les petites formes, hem calculat la seva micromesura, les hem il·lustrat com autèntics botànics i naturalistes, i hem escrit breus poemes per realçar-ne la seva essència celada...
Tot plegat ha estat un estímul per la nostra imaginació i coneixement.
Hem jugat a crear art des de la ciència i a veure la ciència de l’art.
Goethe digué que l’art i la ciència procedeixen de la mateixa font, la natura. L’art és l’intèrpret dels enigmes de l’univers. L’Art i la ciència són objectius. L’obra de l’art, és al mateix temps l’obra de la naturalesa produïda per l’home, segons les lleis naturals i verdaderes. En la persona de Santiago Ramón y Cajal, la seva vocació artística es va fusionar amb la seva vocació suprema, la científica.
Santiago Ramón y Cajal (1852-2003) Ciencia y Arte

LaureAlbin-Guillot, Coupe végétale, c.1931
Què voleu observar?
Iniciem una conversa a l’aula preguntant que els agradaria observar a través del microscòpi.
Èrika: Flors (Pètals)
Joan: Fongs
Jana C: papallones
Paula: Bacteris pantalles del mòbil
Gal·la: pell morta del coll (cèl·lules i bacteris)
Marina: Tija
Carla: mans brutes
Oriol: Pol·len
Esther: Empremtes
Albert: Composició cigars
Olívia: Cultiu sota les ungles
Núria:Cultiu Esponja de maquillatge
Per tal d’organitzar millor el nostre projecte vam decidir dividirnos amb diferents grups. Vam mirar el que estàvem analitzant i vam poder realitzar 5 grups diferents els quals són regne animal, regne vegetal, fongs, cultius e inerts.

L'obra de Robert Hooke, recull observacions
tota mena d'objectes quotidians, estudiats manera no sistemàtica, i ordenats segons criteri de complexitat creixent, des dels objectes més simples fins als més complexos.
Llegim el llibre “Ramón y Cajal -Ara i aquí” del Salvador Macip i de la mà d’ell comprenem com Ramón y Cajal va anar desenvolupant la seva vocació com a metge i com va anar documentant gran part de les seves investigacions a través de la il·lustració. Una de les altres idees que sorgeix a partir de la lectura d’alguns dels seus capítols és l’ús del pollastre com a objecte d’estudi per la seva semblança a l'ésser humà.


La il·lustració com a font de documentació
Els dibuixos com a mitjà d'il·lustració de les observacions microscòpiques
A l'època de Cajal, els científics generalment utilitzaven el dibuix com a mitjà per il·lustrar les seves observacions microscòpiques. Per tant, acceptar les troballes publicades va ser sovint un acte de fe. Els dibuixos histològics revolucionaris de Cajal van ser considerats inicialment per alguns investigadors com a interpretacions artístiques en lloc de còpies precises dels seus preparats histològics. Però els dibuixos de Cajal són sens dubte peces de realitat, còpies fiables de preparacions histològiques que mostren la microorganització del sistema nerviós: la delicada estructura de les cèl·lules nervioses i les seves connexions.

Dissenyem un armariet per guardar les nostres observacions tal i com feien Ramon y Cajal, Robert Hooke i altres científics…



L'obra de Hooke recull observacions de tota mena d'objectes quotidians, estudiats de manera no sistemàtica, i ordenats segons un criteri de complexitat creixent, des dels objectes més simples fins als més complexos.
● Observacions sobre objectes artificials.
● Observacions sobre elements inerts, destacant les descripcions del gel i la neu.
● Observacions del món vegetal com la descripció del suro, els fòssils i el carbó vegetal.
● Observacions sobre el regne animal amb 26 descripcions d'animals i parts d'animals, com ara puces o ull compost de la mosca.
● Tres observacions telescòpiques.
● Observacions clíniques als animals.
● Observacions sobre el que Hooke anomena el “regne dels fongs”, entrin els que es troben les floridures els llevats i els bolets.
Llegim el poema d’en David Jou, que comença “En aquest precís mil·límetre quadrat…”
En aquest precís mil·límetre quadrat, jo, vertiginosament més jove - dies, anys, segons, què hi fa, inabastable ja l’instant que el vers evocavaig sentir-me ple de dons inescrutables.
Quanta aigua sobre el foc d’aquell moment, sobre el trànsit fugacíssim de tantíssima claror! Saviesa, enteniment, consell, fortalesa, ciència, pietat, temor, quart d’exili!
Quanta erosió, pedra de llum d’aquest instant, fins a fer-te sorra amb escorpins, espais desert on vagarejo!
David Jou
Jordina - “En aquest precís mil·límetre quadrat”. Pensem que nosaltres hem estat
utilitzant també aquest mil·límetre quadrat i precisament també ens hem focalitzat en aquest petit espai que ens obriria tot un món.
Paula - “Dies, anys, segons...”. Ens hem
adonat que cada cop que observem pel microscopi en un temps diferent va canviant tot el que veiem, mai arribem a apreciar exactament el mateix. Tots els elements amb vida, com els fongs, per exemple, amb el pas
del temps es van degradant i van canviant la seva forma. També hem treballat altres substàncies o elements que no estan sotmesos al pas del temps com el filtre d’una
cigarreta.
Marc – “L’instant que el vers evoca“. M’ha fet pensar que potser David Jou té una filosofia pròpia de com funciona el temps o com l’interpreta. El temps condiciona tot el que observem i això ens condiciona. També pot parlar del moment precís en el que fa una descoberta meravellosa i és aleshores quan posem tota la força en un vers i convertim aquest sentiment en paraules.
Martí - “Llum-matèria indestriables en la densitat extrema / on les forces van ser una i tot espai fou simetria...“ Fa referència al Big Ban per les forces i la simetria de la física quàntica, que equilibren tot el que observem malgrat es formi de partícules micro. En conseqüència, podem observar tot el que observem, existim gràcies al que no veiem.
Esther – “Tot espai fou simetria”. Fa relació a per exemple a les idees expressades en els tankes. A partir de la nostra observació hem relacionat la imatge micro amb uns patrons que es repeteixen en l’espai. Dins l’observació hi ha molta simetria que podem relacionar amb altres elements visibles a l’ull. De micro a macro hi ha elements molt similars i ens hem adonat d’això.
Jana C - “Saviesa, enteniment, consell, fortalesa, ciència, pietat, temor, quant exili!”. A mi em recorda el procés que hem fet nosaltres. Hem passat per moltes etapes en les que hem pogut anar-ho entenent tot i agafant consell de diversos experts. El primer dia no havíem mirat mai per un microscopi; ara hem pogut fer un gran projecte potenciant tots els nostres coneixements. Ha sigut un trànsit fugaç trobant saviesa, consells, fortaleza perquè hem anant progressant en les idees.
Pensant i estructurant les nostres reflexions hem trobat un altre món ple de simetria diferent. No teníem mai la certesa del que passaria, però al final del procés ens adonem que hem trobat una realitat molt més gran de la que veiem a l’ull nu.
Olívia – “On les forces van ser una”. Em recorda a nosaltres ja que hem anat unint tots els coneixement i l´esforç de la classe per finalment aconseguir una única força per dur a terme el projecte.
Gal·la – “Quanta erosió(...) espai desert on vagarejo”. M’ha fet pensar en l’ull del
microscopi, quan posem una mostra dins del microscopi i anem descobrint tot el que està allà amagat, posem una petita mostra sense certesa del que veurem, però vagarejant anem descobrint tot el que hi ha rere la llum del microscopi.



El dia 22 de febrer va venir la Gemma Navarro, mare de l’Òria i professora de la UB de Biologia. Ens ensenya a fer observacions microscòpiques de cultius de bacteris.

El dia 11 de març va venir a l'escola Esther Sanchez, mare d’una antiga alumna de l’escola. L’Esther ens va explicar una mica de la història de l’art en la ciència ens va realitzar una breu intervenció respecte la seva trajectòria i el que ella es dedicava.
El dia 21 de març va venir a l'escola el Carles Lladó i ens va explicar la importància de la mesura, tot relacionant els conceptes amb la proporcionalitat i l’escala dels dibuixos de les observacions.

Durant tot el procés de documentació hem tingut la intervenció a l’aula de tres experts en diferents àrees del coneixement: el científic de la mà de la Gemma Navarro, mare de l’Òria i professora de la UB de Biologia, la il·lustració científica gràcies a l’Esther Sánchez i finalment, en Carles Lladó, professor de matemàtiques.
La intervenció a l’aula de l’Ester ens porta a dissenyar una tira cronològica de l'ús de la il·lustració al llarg de la història, com a eina per la documentació.







“El visionat de la pel·lícula ens ajuda a entendre, com empraven els dibuixos per representar l’anatomia humana. Des d’òrgans tan importants com el cor, a il·lustracions de l’ull humà que ajudaven a resoldre operacions de catarates.” Jana Alavedra


La tanka es dóna a conèixer en la literatura catalana en la primera meitat del segle XX de la mà de Carles Riba, que en fou un gran conreador. Les tankes parlen principalment de la vida humana, de tot allò vinculat als sentiments de l'ésser humà i la natura. Consta de 31 síl·labes repartides en 5 versos plans sense rima, que segueixen la mesura 5-7-5-7-7. Es compten totes les síl·labes. Si seguim la mètrica catalana, en què es compta fins a l'última síl·laba tònica, podem dir que una tanka és una estrofa que consta de 5 versos de 26 síl·labes repartits seguint la mesura 4’-6’-4’-6’-6’. La gràcia d'aquest poema és crear, en aquest límit d'extensió, una petita imatge ben suggestiva. Alguns consideren que és una ampliació d'un haiku.
Com podem calcular quina superfície real observem a través del microscopi?



Treballem amb 100 augments (10x10)

La importància que té la quadrícula en la representació i en l’escala.

“Mentre es mantingui la proporció és possible passar de micro a macro o al revés.”
Carles Lladó


El significat de la peça recau en el joc que s’estableix amb l’escala, una qüestió científica i universal.





“Quan mirem pel microscopi nosaltres veiem una imatge que ens diu que està ampliada 90 vegades, però només és una impressió òptica que reben els ulls, perquè realment no existeix. En el moment que deixem de mirar aquesta imatge deixa d’existir. Produeix en els ulls un cert efecte que nosaltres identifiquem com a realitat.”
Carles LLadó

Descartes i Kepler, proposaven noves teories òptiques amb la finalitat d’explicar com funcionaven els microscopis i els telescopis en conjunció amb l’ull humà, per a què els observadors poguessin confiar en el que veien a través d’ells. Aquest període de la història es distingeix pel convenciment creixent que el món no és, o no és solament, com sembla ser. Hi ha un nou món visible que s’ha descobert per a l’enteniment.

- Triem imatge que volem observar
- Fotografiem l’observació microscòpica
- La dibuixem
- La comparem amb algun element que coneixem i podem veure a ull nu (món macro)
- Elaborem un tanka parlant d’aquestes imatges i la seva relació
- Creem una obra col·lectiva

Regne animal
- fibra muscular del pollastre (Marc i Martí)
- Teixit connectiu (Abraham)
- Papallona (Jana C i Òria)
- Moll de l’òs (Jordina)
- tendó (Marina)
Persones
- Sang (Bruno)
- Pell del coll (Gal·la)
- Cèl·lules bucals (Mariona)
Cultius
Regne vegetal
- Ceba (Jana A i esther)
- Flor (Aina)
- Espígol (Ruth i Èrika)
- Poma (Júlia i Clàudia)
- Mans brutes
- Barana
- Fulla de llimoner
Inerts
- Cigarreta (albert, Biel, Roc i Bruno)
- Moneda (Pol)
- Mans brutes ((Carla), Barana (Ariadna), ungles (Olívia), esponja de maquillatge (Núria)
El nostre món és micro o macro? Depèn de la perspectiva des d’on el mirem.
L'obra de Hooke recull observacions de tota mena d'objectes quotidians, estudiats de manera no sistemàtica, i ordenats segons un criteri de complexitat creixent, des dels elements més simples fins als més complexos. Nosaltres hem fet una classificació seguint aquest criteri i us mostrem un exemple de cadascun dels regnes observats: el filtre d’una cigarreta (inert), una fulla de llimoner (vegetal), teixit epitelial de pollastre (animal), sang i pell (humanes), fongs i bacteris. Hem observat i fotografiat les mostres microscòpiques i les hem dibuixat. Posteriorment, hem comparat i ens hem adonat que l’estructura de la imatge ens recordava a algun objecte vist a ull nu. Finalment hem elaborat uns poemes inspirats en les tankes, introduïts a la literatura catalana per la mà de Carles Riba, poeta de la nostra classe. Les tankes parlen principalment de la vida humana, de tot allò vinculat als sentiments de l'ésser humà i la natura. Les nostres tankes parlen de micropaisatges reflectits en macropaisatges.
“Descartes i Kepler, proposaven noves teories òptiques amb la finalitat d’explicar com funcionaven els microscopis i els telescopis en conjunció amb l’ull humà, per a què els observadors poguessin confiar en el que veien a través d’ells. Aquest període de la història es distingeix pel convenciment creixent de què el món no és, o no és solament, com sembla ser. Hi ha un nou món visible que s’ha descobert per l’enteniment”.
El ojo del observador Johannes Vermeer, A.Van Leeuwenhoek y la reinvención de la mirada. Laura J.Snyder



sense

 Cigarro (Roc Aguirregabiria, Albert, Biel)
Filtre de tabac
Cigarro (Roc Aguirregabiria, Albert, Biel)
Filtre de tabac
Tu sembles alga, posidònia marina. Tija, arrel, fulles de la Mediterrània. Al fons profund oculta.

Imatge macro
Però ets filtre, filtre de cigarreta.
El fum deflegma
monòxid de carboni.
Ets un moment efímer.

Il·lustració


Observacions ceba microscopi



Tronc aparentes com pell aspra i rugosa. Del pi l’escorça et mostres discontínua, fractal de vida pròpia.
Però ets malla d’essència epidèrmica i moradissa. Ets caliu lacrimogen que et deslliures ingràvid.
Ceba (Esther)

Observacions ceba microscopi


Il·lustració Imatge macro

Basalt simules
cristal·lí i prolífic.
De roques ígnies, monumentals columnes amenaçants de fúria.
Però ets delicada, fragància de la terra.
Ets allium cepa, natura cristal·lina, escates cegadores.

Observació microscopi



Inspiració
Foscos tentacles sobre el marc violeta de primavera.
Com aigua omplen tot l’espai
i com l’amor s’ordenen.
Ets flor morada misteriosa i formosa.
Per l’ull ets simple
i pel micro complexa, plena de fosques taques.



Sembles satèl·lit que tem la llum del dia, però ens il·lumines. Sincronia amb la terra com els cossos celestes
Més ets miceli
etern amb les espores. Sota nosaltres, permanentment habites, com llavor a la terra

Imatge macro

Mostra microscopi


Il·lustració
Un congost sembla, quan l’ànima s'ofega, obscur abisme.
Les tectòniques forces afloren de la terra.
Entre camps liles, Lavandula angustifolia, impavidesa.
Ets somni dins l’essència, ets tota aroma i flaire.
Imatge macro


Observació micro


Il·lustració Imatge macro
Un congost sembla, quan l’ànima s'ofega, obscur abisme. Les tectòniques forces afloren de la terra.
Entre camps liles, Lavandula angustifolia, impavidesa. Ets somni dins l’essència, ets tota aroma i flaire.
Pell del coll, teixit connectiu (Gal·la Garreño)

Observació microscopi






Perla opalina, d’estries congelades, sembles llacuna.
D’argent glaçat abisme, llàgrimes intangibles.
Però ets matèria, epidermis humana, mapa de vida.
Ets embolcall efímer, poema de cèl·lules.
Cultiu de bacteris Observació


Dibuixes línies a sobre el teu cos petri.
Sembles estrella, un equinoderm fòssil, del Cambrià preservada.

Il·lustració Imatge macro
Però ets un regne, un regne de fongs críptic.
Dibuixes línies, Eumicot eucariota, sobre el cos microscòpic.
Papallona (Jana C)


Papallona observada Observació micro

Imatge macro


Il·lustració
Cal·ligrama



Observació micro

Imatge macro
Il·lustració
Pell de girafa
sembla un tapis de taques rar, bell i exòtic, d’assimètriques formes, color de la sabana.
Mes ets punt d’ala, ala de papallona, d’escames plena.
Impressió acolorida vestida d’alegria.
Fibra muscular (Marc Gracia)

Observació fibres musculars del pollastre


il·lustració macro
Camps de sòl auris amb blat que el vent ondula, resplendents conreus.
Cau el sol a la posta, la llum clou fugissera.
Mes ets carn viva, de rural gallinàcia.
la gallina escataina.
Graner molt ple de vida.
Teixit connectiu pollastre (Abraham Cornerjo)
Observació micro

Il·lustració

Imatge macro


Tu mar simules ens inspires moltíssim.
Bonic paisatge d’aigua blava marina fill del Mediterrani .
Teixit connectiu, que embolcalles els òrgans, ens ets molt útil.
T’hem vist al microscopi entre músculs i fibres.


Observació micro

Il·lustració
Estany salini
el teu color simula.
Com clorur sòdic Emets flaire marina
d’algues, argila i terra.

Imatge macro
Dúctil cartílag
ocult al cos. Condròcit.
Teixit de vida.
Tu, que entre els ossos llisques, ets dansa silenciosa.




Observació micro

Daurat miratge d’un desert immutable, font de silici fins l’eternitat dunes. Ets quietud absoluta.
Però no ets sorra. Cèl·lules, que fluctueu destres i àgils, sou l’alè de la força; teixits i músculs formeu.

Cultiu de bacteris

Observació micro
Com lluna plena amb colors tenebrosos magnitud àmplia important cos celeste que il·lumina el cel plàcid.
Lloc de provinença del cultiu
Il·lustració


Però no ets lluna.
Per l’antiga barana, imperceptibles, mil milions de bacteris
Imatge macro




Observació micro Il·lustració Imatge macro

Lloc de provinença de l’observació
Glaçades formes, poden semblar pancake ice d'aigües llunyanes. Com fulles de nenúfars floteu, perles blaunívies
Mes ets bacteri
entre mans brutes creixes, xic procariòtic, organisme antic, simple, Staphylococ aure.

Imatge macro





Observacions micro

Imatge macro

Ulls d’empatia en somnis d’esperança. On humil resta l’àrea cartogràfica
lliure de cruels fronteres.
Dins nucli ossi la realitat es mostra.
Terra de vida en cèlules i càlci ets essència rogenca.



Imatges macro

Sota el roig astre, ets conglomerat únic, història pètria.
Vius el temps que perdures, roca immortal de vida.


Sota l’ull ínfim, tendó teixeix mut, lliure.
Fil prim avança, de força delicada, món invisible, savi.




Observació micro Mostra Il·lustració

Imatge macro
Tu sembles lava, de l’inframon el magma.
Erupció ígnia, de geologia viva; fons terrestres s'albiren,
Mes, ets defensa, sang com rosa morada de glòbuls rojos
i eritròcits en dansa; fas bategar la vida.

micro


Il·lustració

Imatge macro
Gotes que llisquen, aigua bullent simules, camins dibuixes de borbolls i llàgrimes, fills de 100ºC.
Dolços misteris revelats per tu, poma.
Celes, rosàcia de polpa saborosa, secrets dins ta pell fina.

micro


Il·lustració

Imatge macro
Gotes que llisquen, aigua bullent simules, camins dibuixes de borbolls i llàgrimes, fills de 100ºC.
Dolços misteris revelats per tu, poma.
Celes, rosàcia de polpa saborosa, secrets dins ta pell fina.
Fong fulla de llimoner Oriol


Observació micro


Imatge macro Il·lustració
Voleies alta, dins teu creixen molts somnis.
Ets asteràcia, la flor metamorfoses de pètals fins espores.
Mes, fong de fulla ets viu dins blanor fosca.
Secrets soterrats.
Claps nascuts dels micelis, amb míldius que es propaguen.




Observació micro Il·lustració

Flor de xicoia, borrissol flonjo i fràgil, el teu cos sembla.
Família d’asteràcia, amb cops de vent voleies.
Mes no ets planta.
Ets colònia de fongs vius, nascuts de fulles, d’asexuals espores,
dins l'ordre Erysiphales. Imatge

Cultiu Il·lustració
Observació micro



Vora de l’aigua platja deserta, nua.
El sol bressola, les onades murmuren va i ve, dansa d’escuma.
Ets floridura
i no idíl·lic paisatge.
En silenci reposes, dins la placa bategues, emocions em desvetlles. Imatge


Vora de l’aigua platja deserta, nua.



El sol bressola, les onades murmuren va i ve, dansa d’escuma.
Ets floridura
i no idíl·lic paisatge.
En silenci reposes, dins la placa bategues, emocions em desvetlles.
Imatge macro





Branca ofereixes, fronda palmatisecte, amb fruits esfèrics, arbre de xiprer sembla, de la Mediterrània.
En mà tens vàlua, del brut diner ets bacteri.

De Grècia i Roma
Il·lustració Imatge macro
ets gran llegat i història, or, argent, creu o cara.
